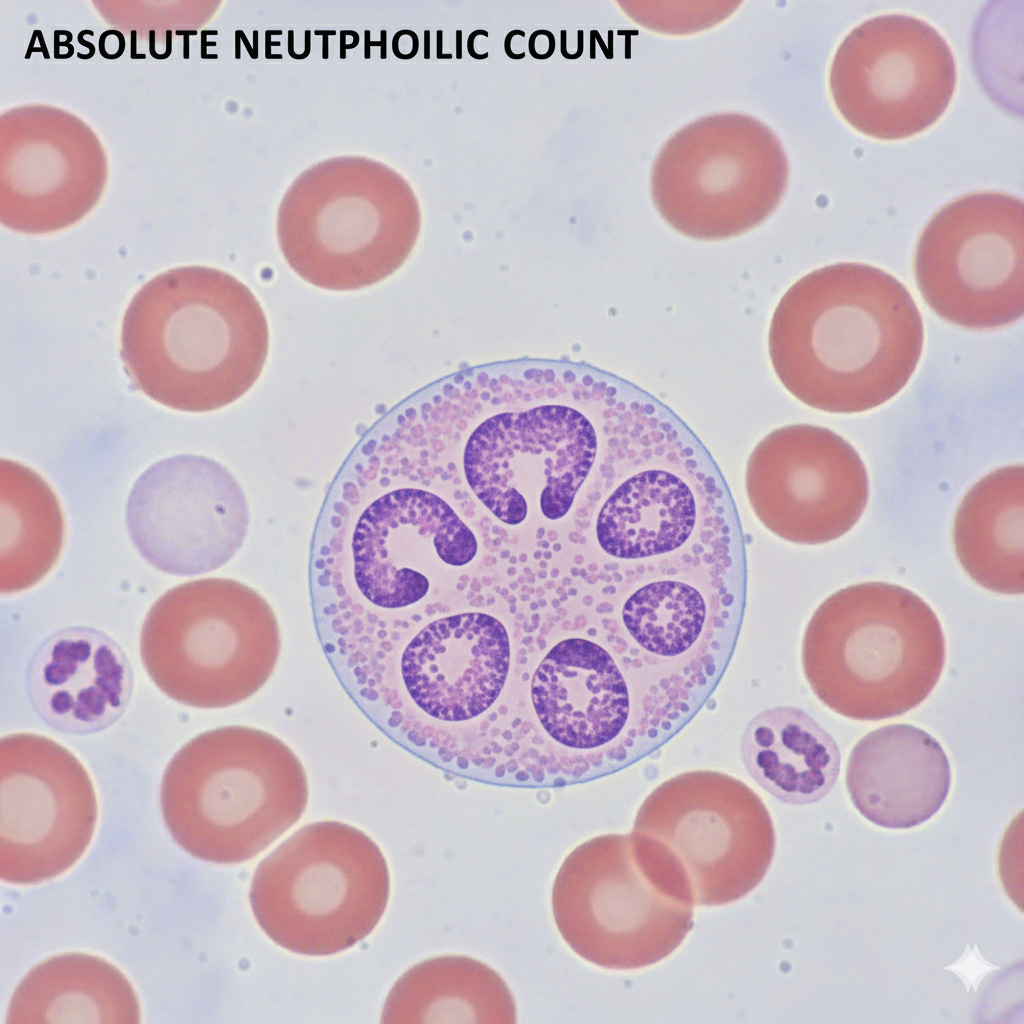

Sale!
Uncategorized
Absolute Neutrophilic Count (ANC)
₹437.00 Original price was: ₹437.00.₹175.00Current price is: ₹175.00.
Category: Uncategorized
Related products
-
Uncategorized
Urine Copper (24 Hours)
₹2,100.00Original price was: ₹2,100.00.₹1,999.00Current price is: ₹1,999.00. -
Uncategorized
Urine Free Cortisol (24 Hours)
₹1,199.00Original price was: ₹1,199.00.₹960.00Current price is: ₹960.00. -
Uncategorized
Urine For Protien (24 Hours)
₹510.00Original price was: ₹510.00.₹399.00Current price is: ₹399.00. -
Uncategorized
Urine For Protein Creatinine Ratio (24 Hours)
₹550.00Original price was: ₹550.00.₹450.00Current price is: ₹450.00.